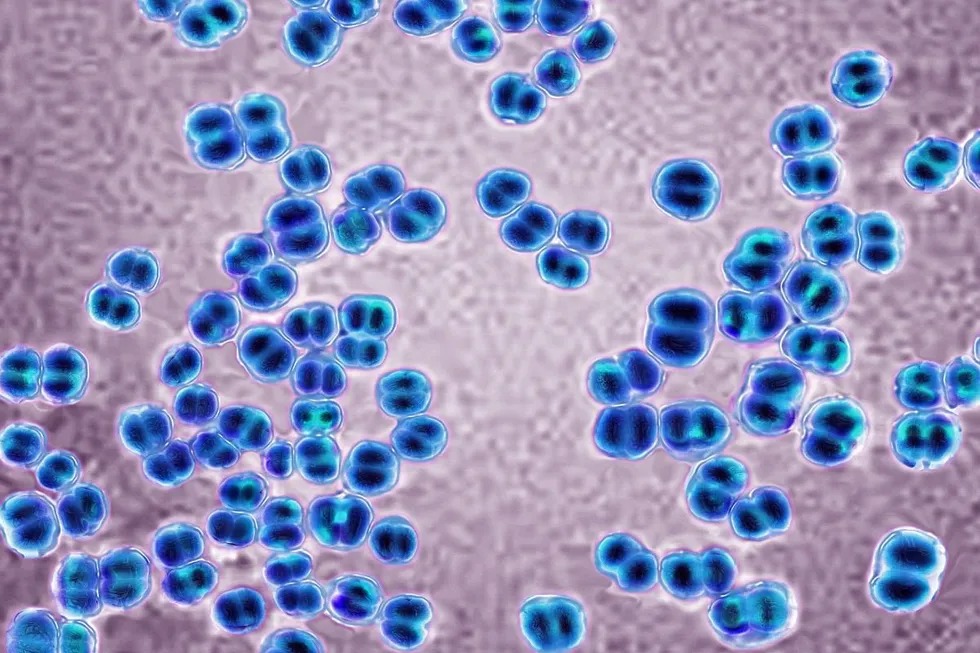
meningitis microscope

Meningitis cases rise to 34 as officials rush to vaccinate thousands amid Easter spread fears
The deadly Kent meningitis outbreak has now reached 34 cases, with health officials confirming 23 infections while 11 additional cases remain under investigation.
In their morning update, the UK Health Security Agency shared new information about the ongoing incident that has so far claimed the lives of two students.
Among the victims is 18-year-old Juliette Kenny, whose family described her as “fit, healthy and strong” prior to her death, alongside another student from the University of Kent.
Health officials are working to determine whether a mutated strain triggered the surge in cases.
At least 13 infections have been confirmed as meningitis B.
The public health director also revealed that 12 university students remain seriously ill in hospital.
Hundreds of young people continued queuing for vaccinations at the Canterbury campus, marking the third consecutive day of mass immunisation efforts as authorities work to contain the spread.
Outside the University of Kent’s Canterbury clinic, more than 400 students and other eligible individuals formed a lengthy, snaking queue as the weekend began.

The number of Meningitis cases has risen to 34 in Kent
|
GETTY
The vaccination centre opened its doors at 9am, though many had arrived considerably earlier. Those positioned near the front reported waiting from 7am, with one person said to have been there since approximately 5am.
Young people bundled in heavy coats and wearing face masks, bracing for what they expected to be an extended wait in the March weather.
By Friday evening, NHS Kent and Medway had delivered nearly 6,000 vaccinations across the county, with a total of 5,794 doses administered.
The antibiotic distribution effort has been even more extensive, with 11,010 courses handed out to those potentially exposed to the infection.
Cases are likely to spread beyond Kent | GETTY
Cases are likely to spread beyond Kent | GETTYSix clinics are currently operational throughout Kent, offering both preventative antibiotics and vaccines to those deemed eligible for treatment.
The scale of the medical response reflects the urgency with which health authorities are treating the outbreak, as they work to protect vulnerable populations and prevent further transmission of the potentially deadly disease.
Dr Ben Rush, consultant in communicable disease control at UKHSA, said: “We continue to remain vigilant for new cases and work closely with NHS England and local authorities across the country to ensure enhanced surveillance is in place. Any new cases will be identified quickly and responded to.”
He emphasised that people must recognise the signs of invasive meningococcal disease and seek immediate medical help if symptoms appear, though the risk to the general public remains low.
 Five schools across the county have also reported confirmed or suspected cases | GETTY
Five schools across the county have also reported confirmed or suspected cases | GETTYHowever, he stressed such cases would be “containable” and the person-to-person transmission risk is minimal.
Kent County Council’s director of public health, Dr Anjan Ghosh, cautioned on Friday that “small household, sporadic clusters” may emerge elsewhere in Britain as students travelling from Kent could “incubate” the bacteria.
The disease typically takes between two and 10 days to develop symptoms after initial infection.
